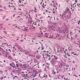
20 cosas que debes saber sobre el cáncer de páncreas.

El corazón es un músculo hueco que forma cavidades en las cuales circula la sangre. Está formado por un músculo con propiedades particulares llamado miocardio, tapizado interiormente por el endocardio y exteriormente por el epicardio contenido en una bolsa fibroserosa llamada pericardio que lo separa de los órganos vecinos.
El corazón está situado en el tórax, detrás de la pared esternocondrocostal, en la parte inferior del mediastino. Se encuentra entre ambos pulmones, rodeados por sus pleuras. Por encima del diafragma, delante de la columna vertebral ( entre la 4a y la 8a apófisis espinosa de las vértebras torácicas (vértebras cardiacas). Situado en la línea mediana, se desarrolla sobre todo a la izquierda de esta línea y poco menos hacia la derecha.
Lo mantienen en su situación los grandes vasos. Por intermedio del pericardio está unido a las diferentes estructuras de la pared torácica o del mediastino. En el interior del pericardio, el corazón está libre.
Tiene la forma de un cono o una pirámide. En él pueden reconocerse:
- Una base, dirigida hacia atrás, arriba y a la derecha.
- Un vértice o punta (ápex) situado adelante y a la izquierda.
Su tejido muscular varia del rosado al rojo oscuro. En su superficie, importantes cúmulos de tejido adiposo se ubican en los surcos del órgano.
Su consistencia en las aurículas, que son delgadas. el corazón aparece blando. Los ventrículos son más resistentes, más elásticos. sobre todo el izquierdo. El corazón es duro durante su período de contracción (sístole). Está más blando y distendido durante la relajación ventricular (diástole). Su consistencia corazón varia también con la edad, con la magnitud del volumen sanguíneo en su interior, así como con ciertas enfermedades que la aumentan o la disminuyen.
El volumen y el peso varían de acuerdo con el sexo y con la edad: el corazón del hombre es más voluminoso que el de la mujer. Al nacer, pesa aproximadamente 25 g; a los 10 años. entre 100 y 125 g y en el adulto entre 200 y 250 g.
Se considera que el corazón tiene cuatro caras, tres bordes, una base y un vértice. Las caras son: anterior o esternocostal, inferior o diafragmática. pulmonar izquierda y pulmonar derecha.
- Cara anterior o esternocostal: Un surco oblicuo, el surco coronario [surco auriculo ventricular) separa las aurículas de los ventrículos y limita dos sectores: el sector auricular y el sector ventricular. Las orejuelas son prolongaciones de las aurículas. La orejuela derecha es cónica. La orejuela izquierda tiene bordes muy irregulares.
- Cara inferior o diafragmática: se aplica sobre el diafragma, tiene forma triangular, dividida por el surco coronario en dos partes, una parte ventricular anterior, y una parte auricular derecha posterior. El segmento ventricular está dividido en sentido longitudinal por el surco interventricular posterior.
- Cara pulmonar izquierda está en contacto a través del pericardio y de la pleura, con la cara medial del pulmón izquierdo, comprende una parte inferior y anterior, ventricular, que pertenece enteramente al ventrículo izquierdo, y una parte superior y posterior que corresponde a la aurícula izquierda.
- Cara pulmonar derecha esta cara está formada por la porción convexa de la pared lateral de la aurícula derecha que se encuentra en relación con la cara medial del pulmón derecho, a través del pericardio y la pleura. Hacia arriba de la aurícula derecha se encuentra la llegada de la vena cava superior, y por debajo de la vena cava inferior.
- La base del corazón es una verdadera cara. Es posterior y está formada por la cara posterior de las dos aurículas, esencialmente por la izquierda. Está dividida en dos partes desiguales por el surco interauricular posterior A su derecha se encuentra la cara posterior de la aurícula derecha, limitada arriba y abajo por los orificios de las dos venas cavas. Estos orificios están reunidos por el seno de las venas cavas. La parte izquierda de la base del corazón corresponde a la cara posterior de la aurícula izquierda. Está marcada por la llegada de las cuatro venas pulmonares.
- Vertice: Es la punta del corazón, que es redondeada, regular y pertenece en su totalidad al ventrículo izquierdo. Los surcos interventriculares, anterior y posterior, se continúan el uno con el otro a 1 o 2 cm a la derecha de la punta. Representa la parte más superficial del órgano que se proyecta a nivel del 4º o 5° espacio intercostal izquierdo, a la altura de la línea mamilar izquierda
El surco interauricular es muy poco marcado. El surco coronario, separa de manera muy evidente el conjunto de las aurículas del conjunto de los ventrículos. Este surco es más marcado porque contiene vasos de diámetro importante: las arterias coronarias y el voluminoso seno coronario. El surco interventricular anterior contiene a la arteria interventricular anterior y a la vena cardíaca magna. Desde la cara inferior, la arteria interventricular posterior, originada de la arteria coronaria derecha y acompañada por la vena cardiaca media, se dirige hacia adelante.